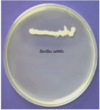
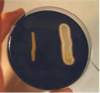
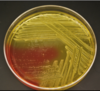
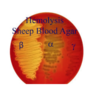

practical 2 Flashcards
(26 cards)
Casen Hydrolysis
- Puroise
- to Detect presense of oriteikytuc ebzymes
- substrate :
- Casein (protein)
- milk oriteub which makes milk white
- Casein (protein)
- Product
- Amino acids (can be transported into cell )
- Indicator
- 15% TCA/ Plate Clearing (precipitates protein )
- Enzyme
- Casease
- peptide bond hydrolysis
- Casease
Gelatin Hydrolysis
- Substrate
- Gelatin
- Product
- Amino Acids
- Enzyme
- Gelatinase
- Indicator
- TCA (zone of clearing )

Starch Hydrolysis
- Substrate
- Starch (glucose polysacch)
- Product
- Glucose and maltose
- Enzyme
- Alfa amalase
- Indicator
- Iodine (zone of clearing)complexes with starch to form blye complex does not complex with hydrolyzed starch
Lipid Hydrolysis
- Substrate
- triglyceride
- Product
- glycerol and Fatty acids
- Enzyme
- lipase ( hydrolase)
- Indicator
- Spirit Blue Agar
- neutral ph pale blue acidic ph dark blue
*
- neutral ph pale blue acidic ph dark blue
- Spirit Blue Agar

HYDROGEN SULFIDE PRODUCTION TEST
- purpose
- used to differentisate sulfur reducing organisms
- sustrate
- cysteine
- thiosulfate
- product
- Cysteine–> Pyruvate and H2S
- Thiosulfate–>H2S
- enzyme
- Cystein–> Cysteine desulfurase
- Thiosulfate redyctase
- indicator
- SIM ( sulfur Indole motility)
- Ferrous ammonium sulfate forms an insoluable black precipitate
- SIM ( sulfur Indole motility)

Bile Esculin test
- purpose
- used to identify organisms capable of growing in presence of bile salts identifies bacteria that can live in the intestine
- sustrate
- esculin
- product
- Beta glucose and Esculetin
- enzyme
- Esculin hydrosyil
- indicator
- ferric ammonium citrate Fe3+–> dark brown

MSA mannitol Salt Agar
- purpose
- sustrate
- Manitol
- product
- Mixed Acid
- enzyme
- Fermentation
- indicator
- penol Red
- 7.5% NaCl in media inhiits the growth of most organisms other than staph
- Pathogenic Staphylococcus aureus yellow – S. epidermidis pink/red
- pH lower than 6.8 indicates the fermentation produce acid end products and the phenol red turns yellow pH higher than 8.4 indicates no fermentation and the media turns pink
BAP Blood Agar Plates
- Purpose
- used for isolation and cultivastion of fastidious bacteria
- substrate
- 5% sheeps blood
- product
- clearing color change
- enzyme
- hemolysin
- indicator
- α-Hemolysis
- Partial destruction or lysis of RBCs • Produces greenish discoloration of the agar around the colonies
- β-Hemolysis
- • Complete destruction or lysis of RBCs • Results in a clearing of the medium around the colonies
- γ-Hemolysis]
- No destruction or lysis of RBCs • Non-hemolysis and appears as simple growth with no change in the medium
- α-Hemolysis
Catalse test
- Purpose
- used to identify organisms that produce enzyme catalase
- some aerobic generate H2O2
- substrate
- 2O2 (superoxide Radical)
- H2O2( hydrogen peroxide)
- product
- H202 +O2
- H20 + O2
- enzyme
- Catalase
- indicator
- H2O2 forms bubles inpresense of catalase
Oxidase
- Purpose
- used to identify organisms containing the respitory enzyme cytochrome c oxidase
- substrate
- TMPD Reduced
- product
- TMPD Oxidized
- enzyme
- Cytochrome C oxidase
- indicator
- Color change
DNase
- Purpose
- used to detect whether organism is capable to produce DNase which can be used to distinguish pathogenic staph
- substrate
- DNA
- product
- Nucleotides
- enzyme
- DNase
- indicator
- DNase agar plate add 1 N HCL
- zone of clearing around bacterial growth
- DNase agar plate add 1 N HCL
Coagulase
- Purpose
- used to identify organisms capable of produciong coagulase
- substrate
- rabbit plasma
- product
- clotting or fibrin
- enzyme
- coagulase
- indicator
- Clotting

ONPG
- Purpose
- to indicate lactose fermentors
- substrate
- ONPG
- product
- Galactose +O-Nitrophenol (yellow at ph 8)
- enzyme
- indicator
Fermentation
- energy producing reactions
- prevents the accumulation of pyruvaate and NADH
- products=Acids Gases or both
-
§ Homolactic fermentation -
- Produces two molecules of lactic acid
-
§ Ethanolic fermentation
- Produces two molecules of ethanol and two CO2
-
§ Heterolactic fermentation -
- Produces one molecule of lactic acid, one ethanol, and one CO2
-
§ Mixed-acid fermentation
- Produces acetate, formate, lactate, and succinate, as well as ethanol, H2, and CO2
ANAEROBIC JAR
Purpose: The anaerobic jar creates an artificial anaerobic environment (devoid of oxygen) which permits the growth of anaerobic bacteria.
Principle: The anaerobic jar employs a chemical reaction to generate hydrogen gas. In the presence of a palladium catalyst, the hydrogen gas will react with free oxygen in the air to form water. This reaction removes the oxygen from the sealed atmosphere. The jar is then incubated at the desired temperature.

CANDLE JAR
Purpose: The candle jar is used to create microaerophilic conditions.
Principle: It is a large screw cap container into which the media is placed along with a candle. The candle is lit and the jar is sealed. The candle will burn and reduce the oxygen concentration.
Eugon or Thioglycollate deeps
- Purpose: To create an aerobic/anaerobic environment, which permits the growth of anaerobic/aerobic bacteria.
- Deeper = less oxygen Thioglycolate (and L-cysteine) = consume oxygen Resazurine that turns pink in the presence of oxygen
- Oxygen gradient –
- Differential: microbes grow in different parts of the tube depending on:
- a- Need (use) oxygen
- b- detoxyfy oxygen (have SOD, catalase or peroxidase)
Oxygen utilization & detoxification define:
a- Strict aerobe: ¨ needs & tolerates O2 ¨
b- Obligate anaerobe (strict): ¨ Does not need nor tolerates O2 ¨
c- Facultative anaerobe: ¨ prefers and tolerates O2 ¨
d- Microaerophile: ¨ needs but does not tolerate too much O2 ¨
e- Aerotolerant anaerobe: ¨ Does not need but and tolerates O2

IMViC
- Purpose
- Identify Family Enterobacteriaceae Enteric bacteria Enterikos in Greek > pertaining to the intestines
Indole test
- Purpose
- Used to identify bacteria capable of producing indole
- Substrate
- tryptophan
- Product
- Indole and Pyruvste
- Enzyme
- tryptophanase
- Indicator
- Kovacs reagent–> cherry red color
*
- Kovacs reagent–> cherry red color

Methyl red test
- Purpose
- Identify organisms that are able to produce acid end prucuts by means of mixed acid fermentatun
- Substrate
- Glucose
- Product
- mixed acids
- Enzyme
- mixed acid fermentation
- Indicator
- methyl red

Voges proskauer
- Purpose
- identify organisms that are able to produce acetoin from degradation of glucose
- Substrate
- Glucose
- Product
- acetoin
- Enzyme
- 2-3 butanediol fermentation
- Indicator
- Barrets A&B

Citrate
- Purpose
- used to determine the ability of an organism to use citrate as its sole carbon source
- Substrate
- Sodium Citrate
- Product
- alkaline metabolic products raises ph Growth
- Enzyme
- Citrate permease
- Indicator
- btomothymol Blue
- Starts with green color ph 6.9 –> blue color ph 7.6
- btomothymol Blue

phenylalanine deamination
- Purpose
- userd to identify organisms that are able to remove the amine group from amino acid phenylalanine
- Substrate
- phenylalanie
- Product
- phenylpyruvic acid
- Enzyme
- phenylalanine deaminase
- Indicator
- FeCl3 –> Green Color

